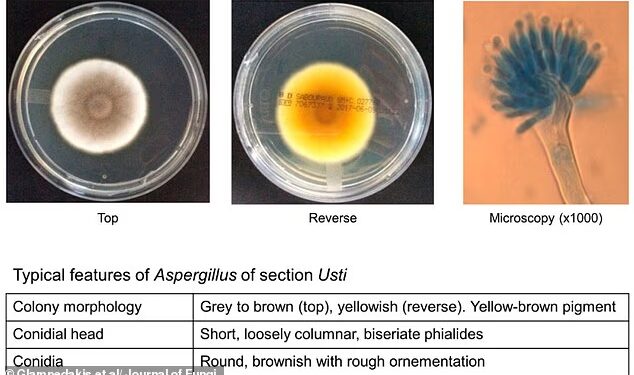

Scientists have long known that fungi are resilient, but research suggests some strains might even survive the long, brutal trip to Mars.
Experts have put fungal microbes through simulations of the harsh conditions experienced during space travel and on the surface of the Red Planet.
The freezing temperatures, ultraviolet rays, ionizing radiation and low atmospheric pressure are enough to kill most living organisms.
But they found the spores of one fungus – Aspergillus calidoustus – survived.
This pathogen produces grey and brown mould and is already known for its resistance to drugs.
It can cause rare but severe and often fatal infections in immunocompromised individuals, such as transplant patients.
The findings suggest the unwanted hitchhiker could catch a ride to other planets and become an invasive species.
And it even managed to get past NASA’s cleanrooms – one of the most sterile places on Earth – without issue.
This pathogen produces grey and brown mould and is already known for its resistance to drugs. It survived simulations of the harsh conditions of space travel. Pictured: A. calidoustus from a previous study
Wiping down hardware is part of the strategy to limit the number of Earth microbes going to other planets. Pictured: Experts working on NASA’s Perseverance rover in a cleanroom ahead of its launch in 2020
This study is the first to show that microbes could persist through every part of a mission to Mars, from preparation to space travel to robotic exploration, the researchers warned.
For the study, the team collected fungal microbes from NASA’s cleanrooms – facilities used in the assembly, testing and launch of spacecraft.
These are ultra–sanitised, highly controlled spaces designed to prevent any form of contamination and to stop unwanted microbes hitching a ride to space.
The researchers generated conidia – asexual reproductive spores – from 27 fungal strains.
These had been isolated from the assembly facilities used in the Mars 2020 program which led to the landing of the Perseverance rover on the Red Planet.
The scientists subjected the conidia to the intense conditions of space travel and Mars, including the loose, dusty rock on the Red Planet’s surface.
And they found the conidia of A. calidoustus tolerated these harsh tests.
‘This does not mean contamination of Mars is likely, but it helps us better quantify potential microbial survival risks,’ study leader Kasthuri Venkateswaran, from NASA’s Jet Propulsion laboratory, said. ‘Microorganisms can possess extraordinary resilience to environmental stresses.’
Only the combination of extreme low temperature and high radiation was able to kill the fungus, the researchers found.
‘Microbial survival is not determined by a single environmental stress but rather by combinations of stress tolerance mechanisms,’ Dr Venkateswaran said.
The study, published in the journal Applied and Environmental Microbiology, builds on previous studies that have identified bacteria and fungi in NASA spacecraft surfaces after decontamination.
‘Together, these investigations help refine NASA’s planetary protection strategies and microbial risk assessment approaches for current and future space exploration missions,’ Dr Venkateswaran concluded.
The major implication with bringing Earth microbes to Mars is that they could be mistaken for alien lifeforms, throwing off decades of research.
There are also concerns that tiny organisms could form colonies in life–support equipment used by astronauts, which could malfunction in a life–or–death situation.
Christopher Mason, a geneticist at Weill Cornell Medicine, has previously spoken of the dangers of transporting microbes to other planets.
He said: ‘It is important to ensure the safety and preservation of any life that might exist elsewhere in the Universe, since new organisms can wreak havoc when they arrive at a new ecosystem.’
Experts recently discovered dozens of tiny living organisms – all previously unknown bacterial species – in the Kennedy Space Center cleanrooms in Florida
Experts recently discovered 26 tiny living organisms – all previously unknown bacterial species – in the Kennedy Space Center cleanrooms in Florida.
‘It was a genuine ‘stop and re–check everything’ moment,’ Alexandre Rosado, a professor of Bioscience at King Abdullah University of Science and Technology (KAUST) in Saudi Arabia , told Live Science .
Analysis of these microbes shed light on how they can live – and even thrive – in one of the harshest man–made environments on Earth.
And it turns out they have genes that help them resist the effects of radiation and even repair their own DNA.